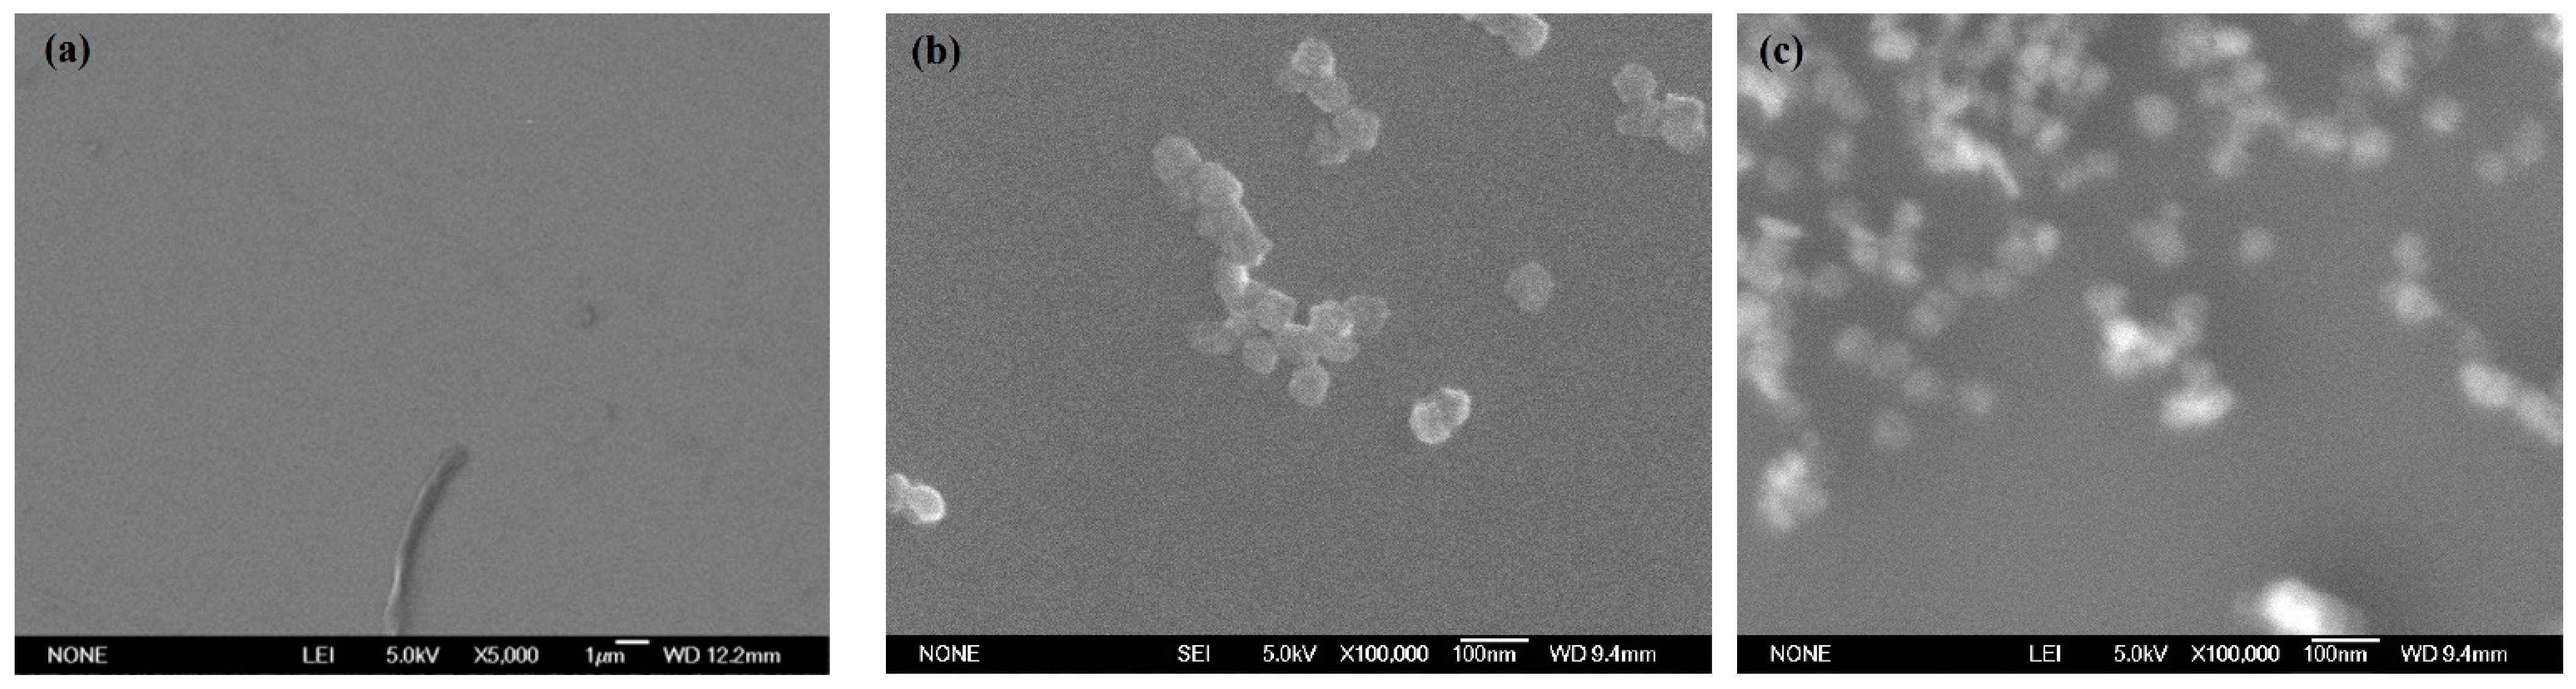
Materials 14 01070 g006 Materials 14 01070 g006

Experimental Investigation on the Effects of Photocatalysis in Ultraviolet-Induced Nanoparticle Colloid Jet Machining
Abstract
1. Introduction
2. Materials and Methods
3. Results
3.1. Characterization of TiO2 Nanoparticles Adsorption on the Si Workpiece Surface
3.2. Polishing Efficiency Comparative Study
4. Discussion
5. Conclusions
Author Contributions
Funding
Institutional Review Board Statement
Informed Consent Statement
Data Availability Statement
Conflicts of Interest
References
- Mori, Y.; Yamamura, K.; Endo, K.; Yamauchi, K.; Yasutake, K.; Goto, H.; Kakiuchi, H.; Sano, Y.; Mimura, H. Creation of perfect surfaces. J. Cryst. Growth 2005, 275, 39–50. [Google Scholar] [CrossRef]
- Mori, Y.; Yamauchi, K.; Yamamura, K.; Mimura, H.; Saito, A.; Kishimoto, H.; Sekito, Y.; Kanaoka, M.; Souvorov, A.; Yabashi, M.; et al. Development of plasma chemical vaporization machining and elastic emission machining systems for coherent X-ray optics. Proc. SPIE 2001, 4501, 30–42. [Google Scholar]
- Luo, J. Variation of surface layer during chemical mechanical polish. Indian J. Pure Appl. Phys. 2007, 45, 403–405. [Google Scholar]
- Belure, A.R.; Biswas, A.K.; Raghunathan, D.; Rishipal Bhartiya, S.; Singh Rashmi Rai, S.K.; Pawade, R.S.; Kamath, M.P.; Benerji, N.S. Development of super-smooth flat silicon mirror substrates using bowl-feed chemical-mechanical polishing. Mater. Today Proc. 2020, 26, 2260–2264. [Google Scholar] [CrossRef]
- Hao, P.; Lei, H.; Chen, R. Cerium-incorporated SBA-15-type materials for CMP: Synthesis, characterisation, and CMP application on hard disk substrate. Int. J. Abras. Technol. 2011, 4, 255–265. [Google Scholar] [CrossRef]
- Li, J.; Liu, Y.; Dai, Y.; Yue, D.; Lu, X.; Luo, J. Achievement of a near-perfect smooth silicon surface. Sci. China Technol. Sci. 2013, 56, 2847–2853. [Google Scholar] [CrossRef]
- Dong, Z.; Ou, L.; Kang, R.; Hu, H.; Zhang, B.; Guo, D.; Shi, K. Photoelectrochemical mechanical polishing method for n-type gallium nitride. CIRP Ann. Manuf. Technol. 2019, 68, 205–208. [Google Scholar] [CrossRef]
- Zhang, F.; Song, X.; Zhang, Y.; Luan, D. Figuring of an ultra-smooth surface in nanoparticle colloid jet machining. J. Micromech. Microeng. 2009, 19, 054009. [Google Scholar] [CrossRef]
- Song, X.Z.; Zhang, Y.; Zhang, F.H. Study on Removal Mechanism of Nanoparticle Colloid Jet Machining. Adv. Mater. Res. 2008, 53–54, 363–368. [Google Scholar] [CrossRef]
- Xu, X.; Luo, J.; Guo, D. Nanoparticle–wall collision in a laminar cylindrical liquid jet. J. Colloid Interface Sci. 2011, 359, 334–338. [Google Scholar] [CrossRef]
- Song, X.; Zhang, Y.; Zhang, F.; Luan, D. Experimental investigation on polishing of ultrasmooth surface in nanoparticle colloid jet machining. Proc. SPIE Int. Soc. Opt. Eng. 2009, 7282, 977–986. [Google Scholar]
- Wang, X.; Zhang, Y.; Qin, X.U.; Cui, Z.M.; Zhang, F.H. Material removal mechanism of nanoparticle colloid jet polishing based on molecular dynamics simulation. China Surface Eng. 2017, 30, 16–25. [Google Scholar]
- Song, X.; Gong, J. Properties of ultraviolet-visible beam propagation in TiO2 nanoparticle colloid. High Power Laser Part. Beams 2015, 27, 024110. [Google Scholar] [CrossRef]
- Song, X.; Yao, T. Effect of nozzle cavity on polishing ability of light coupled colloid jet. Opt. Precis. Eng. 2019, 27, 2011–2019. [Google Scholar] [CrossRef]
- Song, X.Z.; Gao, G.; Zhou, Y.X.; Wang, H.G.; Gong, J. Adsorption of TiO2 nanoparticles on monocrystalline silicon surface. Opt. Precis. Eng. 2016, 24, 1694–1702. [Google Scholar] [CrossRef]
- Song, X.Z. Research on Mechanism and Experiments of Nanoparticle Colloid Jet Polishing. Ph.D. Thesis, Harbin Institute of Technology, Harbin, China, 2010. [Google Scholar]
- Augugliaro, V.; Yurdakal, S.; Loddo, V.; Palmisano, G.; Palmisano, L. Determination of Photoadsorption Capacity of Polychrystalline TiO2 Catalyst in Irradiated Slurry. Adv. Chem. Eng. 2009, 36, 1–35. [Google Scholar]
- Litter, M.I. Treatment of Chromium, Mercury, Lead, Uranium, and Arsenic in Water by Heterogeneous Photocatalysis. Adv. Chem. Eng. 2009, 36, 37–67. [Google Scholar]
- Song, X.; Gao, G. Removal Mechanism investigation of ultraviolet induced nanoparticle colloid jet machining. Molecules 2021, 26, 68. [Google Scholar] [CrossRef] [PubMed]
- Chinh, V.D.; Broggi, A.; Di Palma, L.; Scarsella, M.; Speranza, G.; Vilardi, G.; Thang, P.N. XPS Spectra Analysis of Ti2+, Ti3+ Ions and Dye Photodegradation Evaluation of Titania-Silica Mixed Oxide Nanoparticles. J. Electron. Mater. 2018, 47, 2215–2224. [Google Scholar] [CrossRef]
- Martin, L.; Martinez, H.; Ulldemolins, M. Evolution of the Si electrode/electrolyte interface in lithium batteries characterized by XPS and AFM techniques: The influence of vinylene carbonate additive. Solid State Ion. 2012, 215, 36–44. [Google Scholar] [CrossRef]
- Pabianek, K.; Krukowski, P.; KPolański Ciepielewski, P.; Busiakiewicz, A. Interactions of Ti and its oxides with selected surfaces: Si(100), HOPG(0001) and graphene/4H-SiC(0001). Surf. Coat. Technol. 2020, 397, 126033. [Google Scholar] [CrossRef]
- Zhang, H.; Luo, X.; Xu, J.; Xiang, B.; Yu, D. Synthesis of TiO2/SiO2 core/shell nano cable arrays. J. Phys. Chem. B 2004, 108, 14866–14869. [Google Scholar] [CrossRef]
- Gao, X.; Wachs, I.E. Titania–silica as catalysts: Molecular structural characteristics and physico-chemical properties. Catal. Today 1999, 51, 233–254. [Google Scholar] [CrossRef]
- Leaustic, A.; Babonneau, F.; Livage, J. ChemInform Abstract: Structural Investigation of the Hydrolysis Condensation Proess of Titanium Alkoxides Ti(OR)4 (OR = OPr-iso, OEt) Modified by Acetylacetone Part 2. From the Modified Precursor to the Colloids. Chem. Mater. 1989, 1, 248–252. [Google Scholar] [CrossRef]
- Leaustic, A.; Babonneau, F.; Livage, J. ChemInform Abstract: Structural Investigation of the Hydrolysis-Condensation Process of Titanium Alkoxides Ti(OR)4 (OR = OPr-iso, OEt) Modified by Acetylacetone. Part 1. Study of the Alkoxide Modification. Chem. Mater. 1989, 1, 240–247. [Google Scholar] [CrossRef]
- Capel-Sanchez, M.C.; Blanco-Brieva, G.; Campos-Martin, J.M.; de Frutos, M.P.; Wen, W.; Rodriguez, J.A.; Fierro, J.L.G. Grafting Strategy to Develop Single Site Titanium on an Amorphous Silica Surface. Langmuir ACS J. Surfaces Colloids 2009, 25, 7148–7155. [Google Scholar] [CrossRef]
- Aronne, A.; Fantauzzib, M.; Imparatoa, C.; Atzeib, D.; de Stefanoc, L.; D’Erricod, G.; Sanninoef, F.; Rea, I.; Pirozziaf, D.; Elsenerbg, B.; et al. Electronic properties of TiO2-based materials characterized by high Ti3+ self-doping and low recombination rate of electron–hole pairs. RSC Adv. 2017, 7, 2373–2381. [Google Scholar] [CrossRef]

| Experimental Conditions | Value |
|---|---|
| Workpiece material | Si |
| Nanoparticles material | TiO2 |
| Diameter of nanoparticles | 20–30 nm |
| pH of colloid | 7 |
| Concentration of colloid | 10% (volume percentage) |
| Intensity of pressure | 1 MPa |
| Light intensity | 145 mW/cm2 |
| Injection distance | 4 mm |
| Nozzle diameter | 1 mm |
| Injection time | 3 min |
| Polishing time | 120 min |
| Element (Atomic %) | Original Si Surface | Nanoparticle Colloid Jet Adsorption Surface | UV-Induced Nanoparticle Colloid Jet Adsorption Surface |
|---|---|---|---|
| Si | 46.14 | 41.74 | 13.35 |
| Ti | - | 0.39 | 12.36 |
| O | 30.47 | 31.79 | 41.09 |
| C | 23.39 | 26.08 | 33.2 |
| Sample | Si 2p | Ti 2p | C 1s | O 1s |
|---|---|---|---|---|
| Original Si surface | 98.78 | - | 284.78 | 532.18 |
| 99.28 | ||||
| 102.58 | 286.48 | |||
| Nanoparticle colloid jet adsorption surface and UV- induced nanoparticle colloid jet adsorption surface | 98.78 | 458.58–458.88 | 284.78 | 529.78 |
| 99.28–99.38 | 460.2 | 286.48 | 530.88 | |
| 100.28 | 464.38–464.58 | 288.88 | 532.18 | |
| 102.58 | 533.18 |
| Workpiece | Surface Roughness | Measuring Point 1 | Measuring Point 2 | Average Value |
|---|---|---|---|---|
| Original Si workpiece | Sz | 549 | 758 | 653.5 |
| Sq | 65.6 | 103 | 84.3 | |
| Sa | 50.1 | 83.5 | 66.8 | |
| Nanoparticle colloid jet machining workpiece | Sz | 58.1 | 60.3 | 59.2 |
| Sq | 7.78 | 7.37 | 7.575 | |
| Sa | 6.20 | 5.85 | 6.025 | |
| UV-induced nanoparticle colloid jet machining workpiece | Sz | 52.4 | 48.6 | 50.5 |
| Sq | 5.74 | 5.42 | 5.58 | |
| Sa | 4.57 | 4.31 | 4.44 |
Publisher’s Note: MDPI stays neutral with regard to jurisdictional claims in published maps and institutional affiliations. |
© 2021 by the authors. Licensee MDPI, Basel, Switzerland. This article is an open access article distributed under the terms and conditions of the Creative Commons Attribution (CC BY) license (http://creativecommons.org/licenses/by/4.0/).
Share and Cite
Song, X.; Ge, S.; Wang, X.; Liu, S. Experimental Investigation on the Effects of Photocatalysis in Ultraviolet-Induced Nanoparticle Colloid Jet Machining. Materials 2021, 14, 1070. https://doi.org/10.3390/ma14051070
Song X, Ge S, Wang X, Liu S. Experimental Investigation on the Effects of Photocatalysis in Ultraviolet-Induced Nanoparticle Colloid Jet Machining. Materials. 2021; 14(5):1070. https://doi.org/10.3390/ma14051070
Chicago/Turabian StyleSong, Xiaozong, Shundong Ge, Xiaorong Wang, and Shengkai Liu. 2021. "Experimental Investigation on the Effects of Photocatalysis in Ultraviolet-Induced Nanoparticle Colloid Jet Machining" Materials 14, no. 5: 1070. https://doi.org/10.3390/ma14051070
APA StyleSong, X., Ge, S., Wang, X., & Liu, S. (2021). Experimental Investigation on the Effects of Photocatalysis in Ultraviolet-Induced Nanoparticle Colloid Jet Machining. Materials, 14(5), 1070. https://doi.org/10.3390/ma14051070

